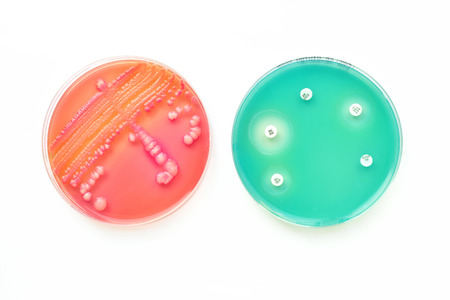
Colonies of bacteria and antimicrobial susceptibility testing in petri dishの写真素材

写真素材 - Colonies of bacteria and antimicrobial susceptibility testing in petri dish
作品情報
Colonies of bacteria and antimicrobial susceptibility testing in petri dish
- ID:54719944
- 作品種別:写真
- 作者名:Jarun Ontakrai
キーワード
- Acinetobacter
- Biology
- Culture
- Disease
- Escherichia
- Laboratory
- MRSA
- Microbiology
- ORSA
- Pseudomonas
- Research
- Science
- Scientific experiment
- Staphylococcus
- Susceptibility
- agar
- antibiotic
- antimicrobial
- aureus
- bacteria
- bacterium
- biochemistry
- chocolate
- coli
- colonies
- colony
- drug
- identification
- identify
- inhibition
- macconkey
- media
- medical
- medical technology
- medium
- microbial
- mycobacterium
- penicillin
- petri dish
- plate
- resistance
- sensitivity
- streptococcus
- test
- zone
類似作品
Red on a blue. ...
subsensitivity ...
Backgrounds of ...
Mixed of bacter...
Drug testing of...
Backgrounds of ...
Backgrounds of ...
chemist wearing...
white fungi on ...
Texture of natu...
Abstract ink te...
Colony Characte...
Scientist growi...
Colony characte...
Backgrounds of ...
Hands holding a...
Different types...
Colony characte...
Backgrounds of ...
Bacterial cultu...
Bacterial cultu...
Staphylococcus ...
Single ornate c...
Backgrounds of ...
Stack of Petri ...
Backgrounds of ...
Backgrounds of ...
Mold Beautiful,...
Characteristics...
Laboratory tech...
Collection of P...
Backgrounds of ...
Backgrounds of ...
Backgrounds of ...
Backgrounds of ...
Antimicrobial s...
Backgrounds of ...
Two Petri dishe...
Staphylococcus ...
different house...
Bacterial colon...
bacteria colony...
fish seafood fa...
Backgrounds of ...
Backgrounds of ...
Petri dish with...
Hand in glove i...
Backgrounds of ...
Petri dishes wi...